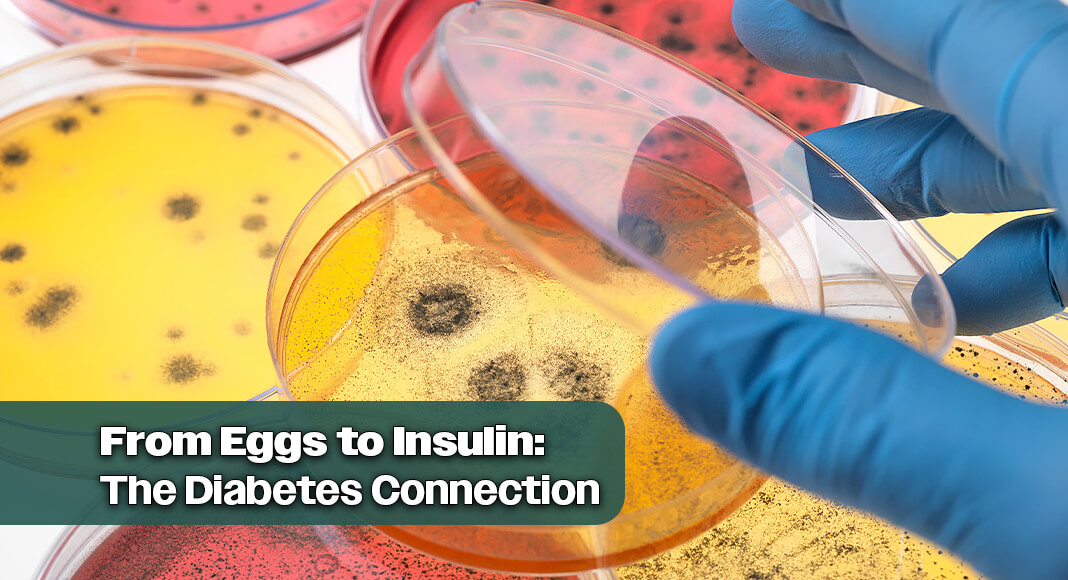
Bacteria in the gut may produce beneficial metabolites when breaking down certain foods. Image for illustration purposes

Mega Doctor News
Medical News Today
Bacteria in the gut may produce beneficial metabolites when breaking down certain foods
Globally, diabetes affects roughly 529 million individuals. In the United States, estimates suggest that more than 30 million people are living with type 2 diabetes.
Type 2 diabetes can develop when the body no longer responds correctly to the hormone insulin. This is known as insulin resistance. Inflammation can cause insulin resistance by triggering the immune system to release signals that block insulin’s action.
This resistance can increase blood sugar and insulin levels, which further fuels inflammation, creating a self-perpetuating state that drives metabolic disease such as type 2 diabetes.
Follow the link below to Medical News Today to read the full stor/y:
Information source: https://www.medicalnewstoday.com









